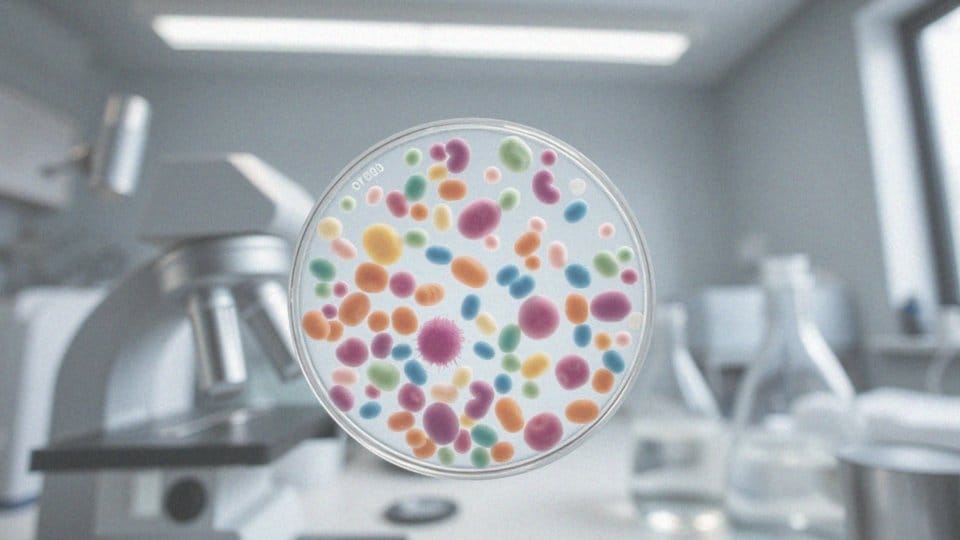

Spis treści
Czy Vigamox to antybiotyk?
Vigamox to preparat stosowany w dziedzinie okulistyki, który skutecznie zwalcza infekcje. Jego głównym składnikiem jest moksyfloksacyna, antybiotyk należący do grupy fluorochinolonów. Dzięki tej właściwości, Vigamox okazuje się efektywny w leczeniu bakterialnych zakażeń oczu.
Działa poprzez inhibicję wzrostu oraz rozmnażania bakterii, co przyczynia się do ustąpienia objawów infekcji. W praktyce, stosowanie Vigamox umożliwia skuteczne pokonywanie różnych zakażeń narządu wzroku.
Warto również podkreślić, że moksyfloksacyna jako substancja czynna stanowi kluczowy element terapeutycznego działania tego leku, co czyni Vigamox cennym środkiem w walce z bakteriami.
Co zawiera i jak działa Vigamox?
Vigamox to lek stosowany w okulistyce, który zawiera moksyfloksacynę – substancję czynną z grupy fluorochinolonów, znaną ze swej skuteczności w zwalczaniu bakterii. Roztwór leku powstaje z:
- kwasu borowego,
- chlorku sodu,
- oczyszczonej wody.
Odpowiednie pH uzyskuje się dzięki zastosowaniu kwasu solnego lub wodorotlenku sodu. Moksyfloksacyna działa na bakterie, mając właściwości bakteriobójcze. Działa poprzez blokowanie enzymów, takich jak:
- gyraza DNA,
- topoizomeraza IV.
Enzymy te odgrywają kluczową rolę w replikacji DNA mikroorganizmów. Utrudniając te procesy, lek zaburza funkcjonowanie bakterii, co skutkuje ich obumarciem. W ten sposób leczenie infekcji oczu staje się bardziej efektywne. Vigamox jest aplikowany bezpośrednio do worka spojówkowego oka, co pozwala na skoncentrowane działanie w miejscu zapalenia. Dzięki swoim właściwościom, ten preparat jest skutecznym rozwiązaniem w walce z różnorodnymi infekcjami okulistycznymi.
Jakie są właściwości przeciwbakteryjne moksyfloksacyny?
Moksyfloksacyna to antybiotyk należący do grupy fluorochinolonów, który charakteryzuje się wieloma właściwościami przeciwbakteryjnymi. Dzięki temu jest uznawany za efektywny lek w różnych dziedzinach medycyny.
Jego działanie bakteriobójcze polega na hamowaniu enzymów gyrazy DNA oraz topoizomerazy IV, które są niezbędne do replikacji i naprawy materiału genetycznego bakterii. Enzymy te odgrywają kluczową rolę szczególnie w przypadku:
- tlenowych drobnoustrojów Gram-dodatnich, takich jak Staphylococcus aureus,
- Gram-ujemnych, do których należy Escherichia coli oraz Klebsiella pneumoniae.
Właśnie to potwierdza szeroki zakres jej działania. Co więcej, moksyfloksacyna jest również skuteczna przeciw niektórym bakteriom beztlenowym oraz atypowym, na przykład Chlamydia trachomatis. Oporność na ten antybiotyk rozwija się rzadko, co czyni go pierwszym wyborem w wielu terapiach.
Dodatkowo, ze względu na korzystny profil dawkowania, znalazła zastosowanie w okulistyce, skutecznie eliminując bakterie odpowiedzialne za zakażenia oczu. W ten sposób stanowi istotny element leczenia infekcji spowodowanych przez różnorodne patogeny w praktyce medycznej.
Jakie bakterie hamuje moksyfloksacyna?
Moksyfloksacyna to niezwykle efektywny lek, który hamuje rozwój wielu różnych szczepów bakterii. Działa zarówno na bakterie Gram-dodatnie, jak i Gram-ujemne, które mogą być przyczyną infekcji oczu. Na przykład skutecznie zwalcza tlenowe mikroorganizmy, takie jak:
- Staphylococcus aureus,
- Staphylococcus epidermidis,
- Haemophilus influenzae,
- Klebsiella pneumoniae,
- Streptococcus pneumoniae.
Dzięki szerokiemu zakresowi działania, moksyfloksacyna interweniuje poprzez blokowanie enzymów niezbędnych do rozmnażania się bakterii, co prowadzi do ich obumierania. W ten sposób skutecznie wspiera leczenie infekcji bakteryjnych oczu i staje się kluczowym elementem terapii w dziedzinie okulistyki.
Jakie działanie bakteriobójcze ma Vigamox?
Vigamox wykazuje działanie bakteriobójcze dzięki zawartości moksyfloksacyny, która blokuje kluczowe enzymy:
- gyrazę DNA,
- topoizomerazę IV.
Te enzymy odgrywają istotną rolę w procesach takich jak:
replikacja, transkrypcja oraz naprawa DNA u bakterii. Kiedy ich aktywność zostaje zahamowana, dochodzi do zakłóceń w metabolizmie komórek bakteryjnych, co ostatecznie prowadzi do ich obumarcia. Lek ten skutecznie eliminuje różnorodne rodzaje bakterii, zarówno tlenowe Gram-dodatnie, jak i Gram-ujemne. Dzięki jego bakteriobójczym właściwościom, Vigamox świetnie sprawdza się w leczeniu bakteryjnych infekcji oczu. Wiele badań klinicznych dowodzi, że objawy zakażeń ustępują w szybkim tempie po rozpoczęciu terapii tym preparatem.
Kiedy stosować Vigamox?
Vigamox to lek, który znajduje zastosowanie głównie w terapii bakteryjnego zapalenia spojówek, spowodowanego przez wrażliwe szczepy mikroorganizmów. Stosuje się go w sytuacjach związanych z ropnymi stanami zapalnymi, a lekarz musi potwierdzić diagnozę przed rozpoczęciem kuracji.
Lek mogą przyjmować zarówno osoby dorosłe, jak i dzieci, które mają więcej niż rok. Kluczowe jest, aby:
- dawki były ustalane przez wykwalifikowanego specjalistę,
- czas leczenia był dostosowany do indywidualnych potrzeb pacjenta.
W przypadku wystąpienia symptomów zapalenia spojówek, takich jak:
- zaczerwienienie,
- wydzielina ropna,
- uczucie dyskomfortu w oku,
wskazana jest natychmiastowa konsultacja ze specjalistą. Użycie Vigamox powinno odbywać się zgodnie z jego przeznaczeniem oraz zaleceniami lekarza. Taki sposób postępowania znacząco podnosi skuteczność terapii oraz minimalizuje ryzyko ewentualnych powikłań. Odpowiednie stosowanie leku pozwala pacjentom na szybsze dostrzeganie poprawy stanu zdrowia oraz efektywne zwalczanie infekcji.
Kiedy nie należy stosować Vigamox?
Vigamox nie jest odpowiedni dla osób uczulonych na jego składniki, takie jak:
- moksyfloksacyna,
- inne leki z grupy chinolonów.
Alergie mogą wywołać poważne reakcje, dlatego ważne jest, aby konsultować się z lekarzem, jeśli masz jakąkolwiek historię uczuleń na substancje czynne zawarte w tym preparacie. Szczególnie ostrożni powinni być ci, którzy doświadczyli reakcji anafilaktycznych lub innych istotnych objawów alergicznych w przeszłości. Przed rozpoczęciem kuracji, warto omówić ze swoim lekarzem wszelkie istniejące schorzenia oraz inne przyjmowane leki. Taka rozmowa pomoże zminimalizować ryzyko wystąpienia interakcji i niepożądanych działań. W przypadku przeciwwskazań lekarz powinien zasugerować alternatywne metody leczenia, które będą dla Ciebie bezpieczniejszym rozwiązaniem.
Jakie są przeciwwskazania do stosowania Vigamox?

Głównym przeciwwskazaniem do stosowania Vigamox jest:
- alergia na moksyfloksacynę,
- alergia na inne substancje z grupy chinolonów,
- alergia na jakiekolwiek składniki preparatu.
Osoby z historią reakcji alergicznych powinny z dużą ostrożnością podchodzić do tego leku, co pozwoli zredukować ryzyko wystąpienia ciężkich reakcji anafilaktycznych. W szczególności, kobiety w ciąży oraz karmiące piersią powinny zachować szczególną ostrożność. Ze względu na ograniczone informacje kliniczne, lekarz musi starannie ocenić zarówno ryzyko, jak i potencjalne korzyści związane z terapeutycznym zastosowaniem tego leku w tych sytuacjach. Dodatkowo, użycie Vigamox w formie wstrzyknięć do oka nie jest zalecane, jako że nie jest to przewidziana forma jego aplikacji. W każdym przypadku wskazana jest konsultacja z lekarzem przed rozpoczęciem kuracji, co pomoże zapewnić bezpieczeństwo oraz skuteczność leczenia.
Jak dawkować Vigamox?
Zalecane dawkowanie leku Vigamox to jedna kropla do zakażonego oka, podawana trzy razy dziennie. Zazwyczaj czas trwania terapii nie powinien przekraczać pięciu dni, jednak lekarz ma możliwość modyfikacji tego okresu, biorąc pod uwagę specyfikę infekcji oraz reakcję pacjenta.
Kluczowe jest przestrzeganie zalecanych odstępów czasowych między kolejnymi dawkami, co znacząco wpływa na efektywność leczenia. Ważne jest również, aby nie przerywać stosowania leku zbyt wcześnie, nawet jeśli objawy ustępują, ponieważ może to spowodować powrót zakażenia. Dawkowanie powinno być starannie monitorowane i dostosowywane przez specjalistę, uwzględniając indywidualne potrzeby pacjenta oraz rozwój stanu zapalnego.
Stosowanie Vigamox w sposób zgodny z zaleceniami przyspiesza proces wyzdrowienia i prowadzi do poprawy ogólnego samopoczucia.
Czy można stosować Vigamox w czasie ciąży i karmienia piersią?

Kiedy rozważasz stosowanie Vigamox w czasie ciąży lub przy karmieniu piersią, niezwykle ważne jest, aby skonsultować się z lekarzem. Moksyfloksacyna, główny składnik tego leku, nie ma wystarczających dowodów klinicznych, które potwierdzałyby jej bezpieczeństwo w przypadkach kobiet w tym szczególnym okresie. Warto, aby specjalista ocenił, czy potencjalne korzyści przewyższają ryzyko dla rozwijającego się płodu lub noworodka. Jeżeli leczenie okaże się konieczne, lekarz z pewnością zaleci używanie Vigamox jedynie wtedy, gdy inne opcje będą niewłaściwe.
Bezpieczniejszym rozwiązaniem jest regularne monitorowanie stanu zdrowia oraz odbywanie konsultacji, co pozwoli na minimalizację ewentualnych negatywnych skutków. Panie w ciąży oraz karmiące powinny zachować szczególną ostrożność przy stosowaniu jakichkolwiek leków, w tym również Vigamox.
Jakie są działania niepożądane Vigamox?
Stosując Vigamox, można napotkać różnorodne d działania niepożądane, które mogą wpływać na komfort użytkowników. Do najczęściej zgłaszanych objawów należą:
- ból i podrażnienie oczu,
- bóle głowy,
- uczucie suchości w oczach,
- problemy z odczuwaniem smaku,
- obniżenie poziomu hemoglobiny,
- parestezje,
- dolegliwości dotyczące rogówki,
- zapalenia powiek,
- obrzęki gałki ocznej,
- zaburzenia widzenia,
- zmętnienie rogówki,
- dyskomfort w obrębie nosa,
- kołatanie serca,
- duszności,
- nudności,
- wysypki skórne.
W przypadku wystąpienia jakichkolwiek niepokojących oznak, warto niezwłocznie skonsultować się z lekarzem. Taki specjalista dokładnie oceni stan zdrowia i podejmie odpowiednie kroki w zakresie dalszego leczenia.
Jakie są metody leczenia zakażeń oka?
Leczenie infekcji oczu jest uzależnione od ich rodzaju oraz stopnia zaawansowania. W przypadku zakażeń bakteryjnych najczęściej sięgamy po krople do oczu z antybiotykami, na przykład moksyfloksacyną (Vigamox). Kluczowe jest szybkie wdrożenie odpowiedniego leczenia, zwłaszcza w przypadku ropnego zapalenia spojówek.
Ważne jest również przestrzeganie zasad higieny, co pomaga zredukować ryzyko zachorowania. Dlatego warto unikać:
- dotykania oczu,
- regularnego mycia rąk,
- dzielenia się ręcznikami ani kosmetykami.
W sytuacji zakażeń wirusowych zastosowanie znajdują leki przeciwwirusowe. Gdy infekcja nie ustępuje, konieczna może być hospitalizacja i dożylne podanie antybiotyków. Szybkie i adekwatne terapie są istotne dla efektywnego leczenia infekcji oczu, co prowadzi do ich szybkiego ustąpienia i zmniejsza ryzyko powikłań.
Jakie są zalecenia dotyczące przechowywania Vigamox?
Przechowywanie leku Vigamox to kwestia, która wymaga staranności, aby zachować jego właściwości terapeutyczne oraz bezpieczeństwo. Ważne jest, aby trzymać go w miejscu, gdzie dzieci nie mają dostępu, co zapobiega przypadkowemu zażyciu. Również uniknięcie temperatur powyżej 25°C jest kluczowe, ponieważ wyższe ciepło może wpłynąć na skład chemiczny leku.
Butelkę warto chronić przed światłem słonecznym, które może prowadzić do degradacji substancji aktywnej. Dlatego najlepiej jest przechowywać ją w oryginalnym opakowaniu. Lek posiada określony termin ważności, który znajdziesz na etykiecie; oznacza to ostatni dzień miesiąca, po którym nie powinno się go już aplikować. Po otwarciu butelki, lek powinien być wykorzystany w ciągu 4 tygodni. Po tym czasie, nawet jeśli nie zużyjesz całego roztworu, zaleca się jego wyrzucenie, aby uniknąć zanieczyszczenia i zminimalizować ryzyko wystąpienia zakażeń oczu.
Czy moksyfloksacyna jest stosowana tylko w okuliistyce?
Moksyfloksacyna to antybiotyk należący do grupy fluorochinolonów, który znajduje zastosowanie w wielu różnych dziedzinach medycyny. W okulistyce najczęściej przyjmuje postać kropli do oczu, takich jak Vigamox, i skutecznie zwalcza bakteryjne zakażenia spojówek.
Oprócz tego, antybiotyk ten stosowany jest w leczeniu:
- infekcji dróg oddechowych,
- problemów skórnych,
- zakażeń tkanek miękkich,
- zakażeń jamy brzusznej.
Lekarz podejmuje decyzję o jego zastosowaniu, biorąc pod uwagę rodzaj infekcji i wrażliwość bakterii na ten preparat. Dzięki szerokiemu zakresowi działania przeciwbakteryjnego, moksyfloksacyna jest cennym narzędziem w walce z różnorodnymi schorzeniami, nie tylko w kontekście okulistyki.







